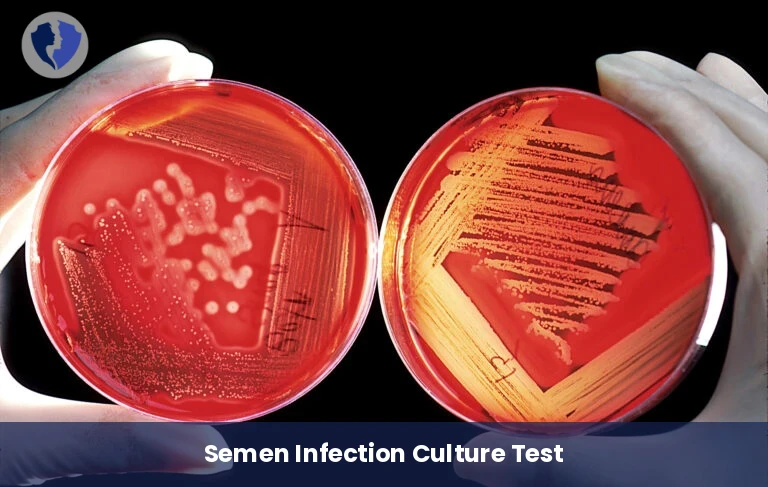
Semen Culture Analysis - Semen Culture and Sensitivity

Service Details
Semen Culture Analysis - Semen Culture and Sensitivity
A semen culture involves culturing a semen sample on a special nutrient medium to detect the presence and number of bacterial or other microorganism colonies. If a microbe is isolated, antibiotic susceptibility testing is performed to determine the most appropriate antibiotic for the guinea pig. This test is used to detect infections of the seminal vesicles, epididymis, or prostate gland that may affect the semen.